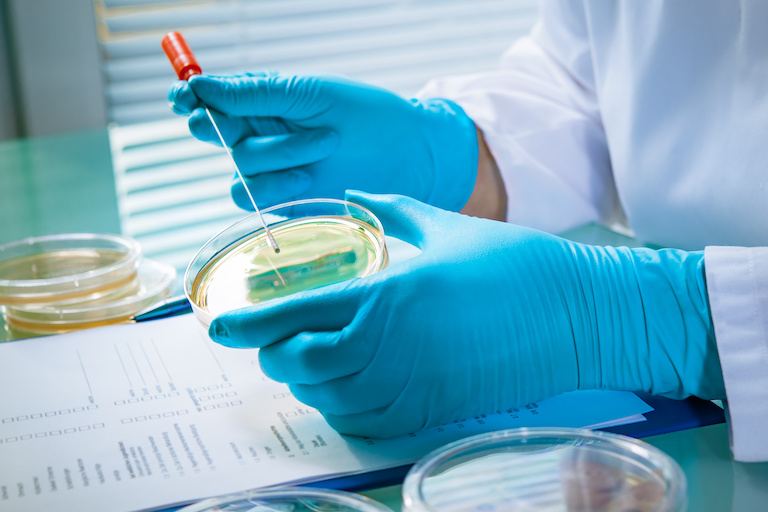
бактерии

Разработкой инновационной методики лечения рака толстой кишки занимается цюрихская группа ученых.
На данный момент о терапии известно мало. В основе методики лежит использование капсул с кишечными бактериями. Молекулярный биолог Ана Монтальбан-Аркес определила группу микроорганизмов, способную укрепить иммунную систему организма человека с тем, чтобы та могла бороться с опухолевыми клетками. В своем ежегодном отчете Университет Цюриха (исследования начались в Университетской клинике Цюриха) назвал это открытие самым важным научным прорывом прошлого года, сообщает 20min.ch.
В лабораторных условиях на мышах удалось продемонстрировать действие кишечных бактерий. Но от первых исследований до появления лекарства могут пройти годы. Клинические испытания, как предполагается, начнутся уже в 2024 году. А само лекарство, возможно, появится не ранее 2029-2030 года.
Ана Монтальбан-Аркес вместе с коллегами Игле Каткевичуте и Филиппом Бузенхартом основали компанию Recolony. В сентябре команда ученых отправится в Бостон, чтобы найти потенциальных партнеров и инвесторов.
Уважаемые читатели «РШ», специально для вас мы запустили канал в мессенджере Telegram. Подписывайтесь на нас — вы будете узнавать новости о Швейцарии, а также свежую аналитику из первых рук и максимально оперативно. Благодарим вас за то, что вы с нами!
Перепечатка текста и фотографий aboutswiss.ch разрешена на условиях размещения ссылки на оригинал материала на нашем сайте.